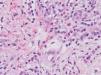

HISTORIA CLINICA
Un paciente varón de 69 años fue remitido a nuestro servicio por lesiones pruriginosas en la espalda y las extremidades de 15 días de evolución. Aunque era aficionado a la apicultura, no recordaba antecedente de picadura ni había introducido recientemente ningún medicamento nuevo. Entre los antecedentes personales destacaba una leucemia linfática crónica (LLC) diagnosticada hacía 8 años, actualmente en estadio A de Binet (estadio O de RAI) que no requería tratamiento en ese momento. Había sido intervenido quirúrgicamente hacía 7 años de un adenocarcinoma de próstata con intención curativa. Estaba en tratamiento con alopurinol, furosemida/triamtereno, parche de nitroglicerina, flecainida, enoxaparina y alprazolam.
EXPLORACION FISICA
A la exploración presentaba un buen estado general, adenopatías axilares y una discreta esplenomegalia. En los flancos y en las extremidades se apreciaban pápulas edematosas con una pequeña vesícula central, en muchos casos erosionada. En las piernas presentaba además ampollas de 2-3 cm de diámetro, de contenido seroso claro o serohemorrágico (fig. 1), algunas de ellas en fase costrosa (fig. 2). No tenía lesiones en mucosas.
Fig. 1.--Detalle de una ampolla serohemorrágica.
Fig. 2.--Pápulas edematosas con centro erosionado junto a una lesión en fase costrosa de mayor tamaño.
EXAMENES COMPLEMENTARIOS
En la analítica destacaba la presencia de 36.800 leucocitos/mm 3 con 81 % de linfocitos; la bioquímica y la coagulación eran normales. Se realizó una biopsia cutánea de una ampolla (fig. 3) y de una pápula edematosa (fig. 4).
Fig. 3.--Ampolla subepidérmica que contiene fibrina, células mononucleares y múltiples eosinófilos. (Hematoxilina-eosina, x10.)
Fig. 4.--En dermis observamos una reacción inflamatoria perivascular e intersticial de células mononucleadas con abundantes eosinófilos.(Hematoxilina-eosina, x40.)
DIAGNOSTICO
Dermatosis eosinofílica asociada a procesos hematológicos de tipo neoplásico o proliferativo (reacción exagerada a picadura de artrópodo en paciente con LLC).
HISTOPATOLOGIA
En la biopsia de la lesión ampollosa se aprecia una ampolla subepidérmica, cuyo techo está constituido por un epitelio parcialmente necrótico con reepitelización y el suelo por las papilas dérmicas. La ampolla contiene fibrina, células mononucleadas y múltiples eosinófilos (fig. 3). En la pápula edematosa existe en la epidermis un intenso edema inter e intracelular, que induce la formación de vesículas basales y ruptura de la membrana basal. En ambas biopsias vemos en toda la dermis reacción inflamatoria perivascular e intersticial de células mononucleadas con abundantes eosinófilos, intensa ectasia capilar y edema (fig. 4). La inmunofluorescencia directa sobre piel perilesional de una ampolla fue negativa.
EVOLUCION Y TRATAMIENTO
A pesar de que el paciente abandonó la apicultura, la evolución desde entonces ha consistido en múltiples rebrotes de lesiones cutáneas que remiten parcialmente con corticoides tópicos. La LLC ha progresado a estadio C por plaquetopenia, pero dada su edad y que está asintomático se ha decidido la abstención terapéutica.
COMENTARIO
Las manifestaciones cutáneas son frecuentes en los pacientes con procesos hematológicos malignos. Éstas se clasifican en específicas (causadas por células neoplásicas) e inespecíficas. Dentro de estas últimas Weed 1 describió, por primera vez, en 1965, una «hipersensibilidad exagerada a picadura de mosquito en LLC». Desde entonces esta dermatosis ha sido mencionada en la literatura en múltiples ocasiones con terminología variada como: «reacción exagerada a picadura de artrópodo en pacientes con LLC» 2,3, «reacción tipo picadura de insecto en pacientes con neoplasias hematológicas malignas» 4, prúrigo linfadénico, «pápulas tipo prúrigo», etc. A pesar de que clínica e histológicamente es compatible con una picadura, la mayoría de las veces el paciente no reconoce este antecedente, por lo que Barzilai et al 4 comentaron la posibilidad de denominar a esta entidad «erupción eosinofílica de los procesos hematológicos», y más recientemente Byrd et al 5 proponen el término: «dermatosis eosinofílica de los procesos mieloproliferativos», evitando así mencionar la picadura. Los criterios diagnósticos que proponen son: a) la presencia de una erupción pruriginosa con pápulas, nódulos y/o vesiculoampollas resistente a tratamientos conservadores; b) un infiltrado linfohistiocitario dérmico rico en eosinófilos; c) descartar otras causas de eosinofilia tisular incluyendo enfermedades ampollosas, infecciones parasitarias, picadura de insecto conocida o reacción medicamentosa, y d) existencia de una discrasia o neoplasia hematológica conocida o su desarrollo posterior. Esta reacción se ha visto en pacientes infectados por el virus de la inmunodeficiencia humana (VIH) 6 y diversas enfermedades hematológicas 3,4 como la agammaglobulinemia congénita 7, la linfocitosis natural killer 8, etc., pero es la LLC la que se asocia con mayor frecuencia, quizá porque es la leucemia más prevalente en los países occidentales o porque los linfocitos B neoplásicos alterados tengan relación con la etiopatogenia 4.
La LLC está englobada dentro de los síndromes linfoproliferativos, por lo que creemos que el término que propone Byrd («dermatosis eosinofílica asociada a síndromes mieloproliferativos») es incorrecto. Por eso proponemos el término «dermatosis eosinofílica asociada a procesos hematológicos de tipo neoplásico o proliferativo», el cual englobaría todos los procesos en los que ha sido descrito.
Su etiopatogenia es desconocida. Barzilai et al 4 destacan que la mayoría de los procesos hematológicos en que aparece esta reacción se originan de células B (LLC, linfoma del manto, linfoma de células grandes y leucemia linfoblástica aguda). Consideran que el mecanismo común consistente en un desequilibrio en el balance de las citocinas, con un exceso de interleucina 4 (IL-4) e IL-5, originaría una proliferación de células B y una respuesta inmune alterada caracterizada por un infiltrado de eosinófilos. Las células B neoplásicas serían por tanto las responsables de la reacción de hipersensibilidad cutánea. Davis et al 3 postulan que la inmunodeficiencia de estos pacientes combinada con algún estímulo inmunológico como puede ser la picadura de insecto, un fármaco o un virus 9, provocaría una respuesta inmune alterada, con secreción aumentada de IL-5. Ello implicaría una reactividad exagerada de los eosinófilos, que a través de una cascada de las citocinas daría lugar a la vasodilatación y extravasación que se corresponden clínicamente con las lesiones descritas, e histológicamente, con un infiltrado linfohistiocitario rico en eosinófilos. Se ha visto que cuanto mayor número de eosinófilos hay en el infiltrado, mayor es el edema y mayor probabilidad hay de formarse lesiones vesiculoampollosas 9.
Clínicamente son lesiones papulosas, nodulares o vesiculoampollas, pruriginosas y en ocasiones dolorosas, de tamaño variable, que se localizan con mayor frecuencia en áreas fotoexpuestas y evolucionan a brotes.
Se debe hacer el diagnóstico diferencial con: erupción medicamentosa, lesión específica de leucemia, enfermedad ampollosa, foliculitis eosinofílica y síndrome de Wells. En nuestro caso descartamos una erupción medicamentosa, ya que el paciente no había introducido nueva medicación; se descartó una enfermedad ampollosa porque la inmunofluorescencia directa fue negativa y se desestimó una lesión específica porque la histología no lo sugería.
El tratamiento es poco satisfactorio: la mejoría es escasa y las recidivas frecuentes. Se ha probado tratamiento corticoideo tópico, pero con frecuencia hay que instaurarlo vía oral, consiguiendo una mejoría espectacular, pero las recidivas son constantes al suspenderlo. Se ha visto mejoría con el tratamiento quimioterápico específico 3-5, aunque algunos creen que puede ser porque en estas pautas terapéuticas está incluido un corticoide. Otras posibilidades son la dapsona 5 y la fototerapia (PUVA 10 y UVB de banda estrecha 4).
La importancia de esta reacción radica en que puede sugerir una progresión de la enfermedad subyacente o hacer sospechar su diagnóstico si no estaba previamente diagnosticada 3,6,11. Por tanto, ante un paciente con esta reacción cutánea, sobre todo si ésta es muy intensa y recidivante, debemos descartar la progresión de su enfermedad hematológica o sospecharla si no estaba diagnosticada.
Declaración de conflicto de intereses
Declaramos no tener ningún conflicto de intereses.
Correspondencia:
P. de Unamuno. Cuesta de Sancti Spiritus, 6, 3.º B. 37001 Salamanca. España.
unamunop@usal.es
Recibido 16 de junio de 2005.
Aceptado 14 de febrero de 2006.